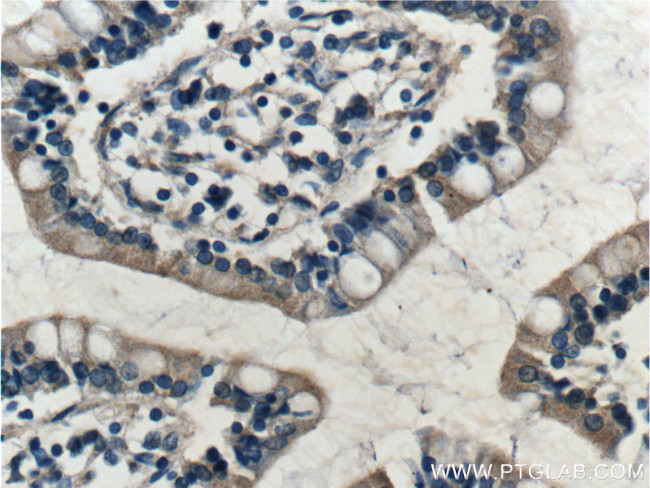
RAMP1 Antibody in Immunohistochemistry (Paraffin) (IHC (P))

Search
Proteintech
RAMP1 Polyclonal Antibody
{{$productOrderCtrl.translations['antibody.pdp.commerceCard.promotion.promotions']}}
{{$productOrderCtrl.translations['antibody.pdp.commerceCard.promotion.viewpromo']}}
{{$productOrderCtrl.translations['antibody.pdp.commerceCard.promotion.promocode']}}: {{promo.promoCode}} {{promo.promoTitle}} {{promo.promoDescription}}. {{$productOrderCtrl.translations['antibody.pdp.commerceCard.promotion.learnmore']}}
产品信息
10327-1-AP
种属反应
已发表种属
宿主/亚型
分类
类型
抗原
偶联物
形式
浓度
规格
纯化类型
保存液
内含物
保存条件
运输条件
产品详细信息
Immunogen sequence: MARALCRLP RRGLWLLLAH HLFMTTACQE ANYGALLREL CLTQFQVDME AVGETLWCDW GRTIRSYREL ADCTWHMAEK LGCFWPNAEV DRFFLAVHGR YFRSCPISGR AVRDPPGSIL YPFIVVPITV TLLVTALVVW QSKRTEGIV (1-148 aa encoded by BC000548 )
靶标信息
The protein encoded by this gene is a member of the RAMP family of single-transmembrane-domain proteins, called receptor (calcitonin) activity modifying proteins (RAMPs). RAMPs are type I transmembrane proteins with an extracellular N terminus and a cytoplasmic C terminus. RAMPs are required to transport calcitonin-receptor-like receptor (CRLR) to the plasma membrane. CRLR, a receptor with seven transmembrane domains, can function as either a calcitonin-gene-related peptide (CGRP) receptor or an adrenomedullin receptor, depending on which members of the RAMP family are expressed. In the presence of this (RAMP1) protein, CRLR functions as a CGRP receptor. The RAMP1 protein is involved in the terminal glycosylation, maturation, and presentation of the CGRP receptor to the cell surface.
仅用于科研。不用于诊断过程。未经明确授权不得转售。
生物信息学
蛋白别名: calcitonin receptor-like receptor activity modifying protein 1; Calcitonin-receptor-like receptor activity-modifying protein 1; CRLR activity-modifying protein 1; MGC38240; RAMP1; receptor (calcitonin) activity modifying protein 1; receptor (G protein-coupled) activity modifying protein 1; Receptor activity-modifying protein 1; type I transmembrane protein
基因别名: RAMP1
UniProt ID: (Human) O60894
Entrez Gene ID: (Human) 10267